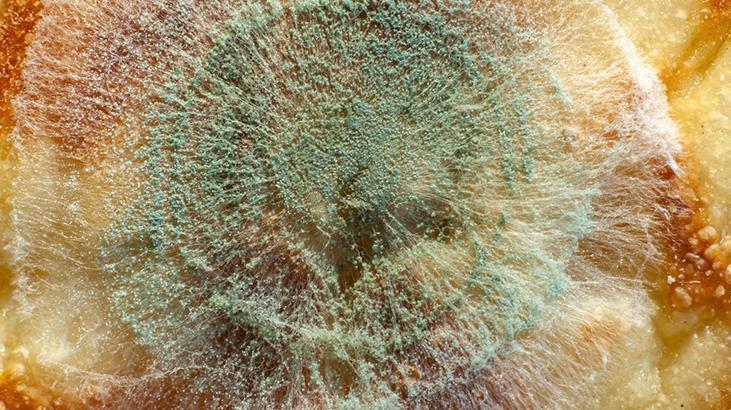

Küf sessizce meskeninize yerleşiyor! Birinci işareti banyoda arayın, ciğeriniz için koşul


Evinizin etrafında küf oluşumu aramak fikrinden hoşlanmasanız da, bir sorun olduğundan şüpheleniyorsanız (özellikle de alanınız yetersiz havalandırmaya ve yüksek nem düzeylerine sahipse), o vakit mümkün olan en kısa müddette sorunun temeline inmeniz gerekir.
Evinizde küf oluşumu olup olmadığını nerede arayacağınızı bilemiyor olabilirsiniz. Muhtemelen denetim etmeyi hiç düşünmeyeceğiniz bir nokta da küfler gizlenmiş olabilir. Küften şüpheleniyorsanız birinci evvel denetim etmeniz gereken yer banyonuzdur.

Banyoyu denetim ettikten sonra mutfakta musluklarınıza, halı döşemelerinin altına, tavan ortalarına, bulaşık makinelerinin yahut çamaşır makinelerinin altına yahut gerisine, dolapların içi, bilhassa saklama kapları ve giysilerle gizlenmiş alanlara, havalandırma deliklerine ve hava akışının az olduğu yahut hiç olmadığı ve toz birikiminin olduğu yerlere bakabilirsiniz.

Evinizde bir küf sorunu keşfettiyseniz, dikkate almanız gereken birkaç farklı şey vardır. Birincisi küf sıkıntısının boyutudur. Küflü alanın boyutu bir metre kare yahut daha azsa, sorunu muhtemelen kendiniz halledebilirsiniz ve daha büyükse, bir profesyoneli aramalısınız.

Ancak, sıhhat sıkıntılarınız varsa yahut sorunu kendiniz halletme konusunda kendinizi rahat hissetmiyorsanız, bunu profesyonellere bırakmak asla berbat bir seçim değildir.

Bir öteki konu, küfün üzerinde büyüdüğü öğenin materyali, yüzeyi ve temizlenip temizlenemeyeceğidir. Halı yahut hatta tavan döşemeleri üzere emici, gözenekli materyaller büsbütün atılmak zorunda kalabilir zira küf gözenekli materyallerin çatlaklarına derinlemesine sızabilir ve bu da onları düzgünce temizlemeyi zorlaştırır.

Son olarak, kendi başınıza yapacağınız rastgele bir küf paklığında, havadaki küfe maruz kalmanızı sınırlamak için gözlük, eldiven ve maske üzere ferdî gözetici ekipman kullandığınızdan emin olmayı unutmayın.




